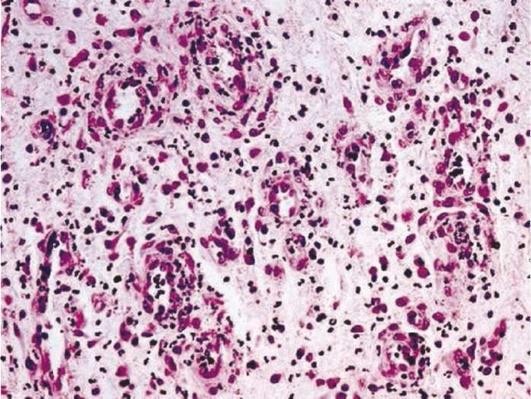
image57

Патологическая анатомия. Т. 1. [Электронный ресурс]: учебник: в 2 т. / под ред. Паукова В.С. - М. : ГЭОТАР- Медиа, 2020. |
Аннотация
Учебник написан группой опытных преподавателей кафедры патологической анатомии им. акад. А.И. Струкова Первого МГМУ им. И.М. Сеченова при участии ведущих специалистов ряда других медицинских университетов. Изложение проблем общей и частной патологической анатомии основывается на принципе единства структуры и функции. Авторы старались показать не только морфологическую основу патологических процессов и болезней, но и их связь с изменениями функций организма, что проявляется в определенных симптомах заболеваний, показать динамику их развития. Это создает базу для последующего изучения всех клинических дисциплин.
В книге, кроме патологической анатомии, описаны общемедицинские понятия, правила написания клинического и патологоанатомического диагнозов, категории и причины расхождения диагнозов и др. Все это способствует развитию у студентов клинического мышления, которое возможно только на основе глубоких знаний и понимания закономерностей развития патологических процессов в больном организме. Тем самым патологическая анатомия является важнейшим этапом подготовки врача, и учебник "Патологическая анатомия" соответствует этой задаче.
Предназначен студентам лечебного, педиатрического, медико-профилактического и стоматологического факультетов медицинских вузов.
Воспаление - комплексная местная сосудисто-мезенхимальная реакция на повреждение, вызванная действием различного рода агентов. Это биологический и один из ключевых общепатологических процессов, целесообразность которого определяется защитно-приспособительной функцией, направленной на ликвидацию повреждающего агента и восстановление поврежденной ткани. Для обозначения воспаления в большинстве случаев к названию органа или ткани присоединяют окончание «ит» (itis - в латинской транскрипции). Так, воспаление миокарда обозначается как миокардит, плевры - плеврит, воспаление печени - гепатит, мышечной ткани - миозит и т.п. Вместе с тем воспаление некоторых органов носит название, отражающее старые традиции - воспаление зева называют ангиной, воспаление легких - пневмонией, воспаление полостей - эмпиемой и др.
Не вызывает сомнения, что воспаление существует столь же долго, как и жизнь на Земле. Принято считать, что история учения о воспалении началась с Гиппократа (460-377 гг. до н. э.), хотя, несомненно, и ранее люди знали об этом процессе. Римский ученый А. Цельс (25 г. до н. э.- 50 г. н. э.) выделил основные внешние симптомы воспаления: красноту (rubor), опухоль (tumor), жар (calor) и боль (dolor). Позже К. Гален прибавил еще один признак - нарушение функции (functio laesa). Свой вклад в понимание воспаления и механизмов его развития внесли голландский врач ХVII в. Г. Бурхаве, австрийский патологоанатом К. Рокитанский, немецкий патолог Р. Вирхов и др. Принципиальным шагом в изучении воспаления стала фагоцитарная теория И.И. Мечникова, явившаяся основой для учения о клеточном иммунитете. За эти исследования И.И. Мечников и П. Эрлих, разработавший теорию гуморального иммунитета, в 1908 г. получили Нобелевскую премию.
И.И. Мечников первым показал, что воспаление - важнейшая приспособительная реакция организма. Позже стало понятно значение в воспалении реактивности и аллергических реакций. Была раскрыта сущность феномена Артюса, а К. Пирке в 1907 г. предложил использовать эту гиперергическую реакцию в качестве диагностического теста. Р. Ресле в 1914 г. показал, что в основе подобных реакций лежит экссудативное воспаление и назвал его гиперергическим. К середине ХХ в. произошло сближение понятий о воспалении и иммунитете. Изучение их взаимодействия позволило А.И. Струкову сформулировать понятие об иммунном воспалении. Были детально изучены физиологические реакции, обеспечивающие воспаление и его регуляцию. Появление новых методов исследования позволило раскрыть тонкие механизмы воспалительного процесса, особенно на ультраструктурном и молекулярном уровнях. С помощью молекулярной биологии уточнена роль межклеточных отношений в развитии воспаления, что позволило расширить арсенал методов его лечения. В настоящее время большинство специалистов считает, что воспаление - это возникшая в ходе эволюции сложная местная реакция организма на повреждение. Она проявляется характерными изменениями микроциркуляторного русла и мезенхимы и на определенном этапе развития вызывает включение комплексных регулирующих систем.
Значение воспаления для организма неоднозначно. Хотя защитно-приспособительный характер воспаления можно считать доказанным, тем не менее и сейчас некоторые исследователи подчеркивают лишь относительную целесообразность воспаления и несовершенство этой реакции, так как воспаление может привести больного к смерти. Однако если воспаление существует так же долго, как и жизнь на Земле, то возникает вопрос - может ли несовершенная реакция существовать миллионы лет? Еще Ч. Дарвин (1859) доказал, что все несовершенное в процессе эволюции погибает. И.В. Давыдовский показал, что как совершенная приспособительная реакция воспаление выступает прежде всего по отношению к человечеству как биологическому виду, ибо через воспаление человечество приобретает новые свойства, которые помогают ему приспособиться к меняющимся условиям окружающей среды, например, сформировать врожденный и приобретенный иммунитет. Однако для конкретного человека воспалительная реакция нередко принимает черты болезни, так как его индивидуальные приспособительные и компенсаторные возможности в силу различных причин (возраст, другие болезни, сниженная реактивность и т.п.) оказываются недостаточными, и именно эти индивидуальные особенности человека в условиях конкретной болезни способствуют его смерти. Но из-за особенностей организма конкретного больного само воспаление не теряет своего совершенства. Кроме того, видовые реакции, присущие всем индивидам, составляющим вид, всегда имеют приоритет над индивидуальными, так как для природы важно сохранение именно вида, а человек изначально смертен и поэтому его смерть не имеет существенного значения для биологического вида и природы в целом. Следует также отметить, что абсолютно совершенных приспособительных реакций быть не может, ибо в противном случае человек стал бы бессмертным. Если же подходить к воспалению с позиций видовой целесообразности, то воспаление, безусловно, совершенная защитно-приспособительная реакция, направленная на сохранение жизни человека как представителя биологического вида. Вместе с тем и до настоящего времени не все механизмы развития воспаления изучены окончательно.
Воспаление и иммунитет
Биологический смысл воспаления заключается в отграничении и ликвидации очага повреждения и вызвавших его патогенных факторов, а также в репарации поврежденных тканей. Тот же биологический смысл имеют реакции иммунитета, так как конечный результат и воспаления, и иммунитета направлен на избавление организма от патогенных раздражителей. Поэтому между воспалением и иммунитетом существует как прямая, так и обратная связь. И воспаление, и иммунитет направлены на очищение организма от чужеродного фактора или измененного своего (некротизированные собственные ткани, иммунные комплексы, токсичные продукты азотистого обмена и т. п.) с последующим отторжением повреждающего фактора и ликвидацией последствий повреждения. Кроме того, при воспалении происходит высвобождение антигенных структур повреждающего агента или поврежденных тканей, что приводит к зарождению иммунных реакций. В то же время сами иммунные реакции реализуются через воспаление, а от выраженности иммунного ответа зависит судьба воспалительной реакции. Когда иммунные средства защиты от внешних или внутренних воздействий эффективны, воспаление может вообще не развиться. При возникновении реакций гиперчувствительности воспаление служит их морфологическим проявлением. Если причиной и началом воспаления является реакция иммунной системы, то развивается иммунное воспаление. Характер воспаления в значительной степени зависит от особенностей иммунитета или степени иммунного дефицита. Например, у животных, имеющих дефекты T-лимфоцитов (так называемые nude-мыши), практически нет ограничительной воспалительной реакции на воздействие гноеродных микроорганизмов, и животные погибают от сепсиса. Аналогичная реакция происходит у людей с врожденным иммунодефицитом (при синдромах ди Джорджи, Вискотта-Олдрича, Луи-Барр и др.).
Существует мнение (В.С. Пауков), что воспаление и иммунитет представляют собой единую систему защиты организма, состоящую из двух компонентов: немедленных неспецифических реакций воспаления и последующих специфических реакций иммунитета. Для выявления антигенов, попавших в организм, необходимо вначале фагоцитировать возбудителей, определить их антигенные детерминанты, передать информацию об этих антигенах иммунокомпетентным органам. Только после этого происходит стимуляция иммунной системы. Все эти процессы возникают при воспалении и при этом уже начинаются изоляция возбудителей и их уничтожение. Эта неспецифическая защита позволяет организму сдерживать агрессию до развития первичного иммунного ответа (в среднем 10-14 сут). За это время происходят трансформация B-лимфоцитов в плазматические клетки, синтез плазмоцитами специфических Ig, образование и гиперплазия необходимого количества T-лимфоцитов и т.п. Лишь после этого реагируют механизмы специфической иммунной защиты, и она реализуется также через воспаление. В итоге достигается основная задача и воспаления, и иммунитета - ликвидация патогенного фактора. Последующая репарация поврежденных тканей также происходит через продуктивную фазу воспаления.
Взаимоотношения между воспалением и специфическими реакциями иммунной системы сложны. Так, при активации системы фагоцитирующих мононуклеаров (макрофагов) происходит формирование вокруг очага воспаления более мощной соединительнотканной капсулы в более ранние сроки. В то же время угнетение функций системы макрофагов способствует увеличению зоны некроза и нагноения, меньшей выраженности соединительнотканной ограничительной капсулы. Использование лекарственных препаратов, стимулирующих клеточный иммунитет, ведет к более быстрому заживлению гнойных ран. При воспалении возникают сложные взаимодействия иммунной и нейроэндокринной систем. Их участие в этом процессе подтверждается наличием на клеточных мембранах иммунокомпетентных клеток и лейкоцитов адренергических рецепторов, разнонаправленное действие на воспаление симпатической и парасимпатической нервной системы, регулирующее влияние гипоталамуса на иммунитет.
Воспаление также зависит от реактивности организма, не отделимой от иммунитета. Воспалительная реакция в различные периоды жизни человека имеет особенности. Так, с рождения до окончания пубертатного периода происходит формирование иммунной системы, еще нет баланса регулирующих систем организма, прежде всего иммунной, эндокринной, нервной, поэтому недостаточно выражены отграничение воспалительного очага и репарация поврежденной ткани. Это объясняет склонность к генерализации воспалительного и инфекционного процессов у детей. В пожилом возрасте возникает сходная воспалительная реакция из-за снижения иммунной защиты организма. На характер воспаления также влияет наследственность, особенно лейкоцит-ассоциированные антигены (HLA - human leukocytes antigenes) главного комплекса гистосовместимости. Таким образом, сможет ли воспаление выполнить свое назначение как защитно-приспособительная реакция или оно окажется губительным для больного, зависит от многих особенностей организма, но прежде всего от его реактивности, которая в свою очередь обусловлена многими другими факторами, наследственными и приобретенными, на протяжении жизни. В этом проявляется диалектическая сущность воспаления как одной из основных защитно-приспособительных гомеостатических реакций организма.
Этиология воспаления
Воспаление может быть вызвано многими биологическими, физическими и химическими факторами, от которых в значительной степени зависят характер и особенности воспаления. Эти факторы могут быть как экзогенными, так и эндогенными. К биологическим факторам следует отнести чрезвычайно широкий спектр различных возбудителей, начиная от вирусов и вплоть до животных-паразитов. Воспаление вызывают также циркулирующие в крови антитела и иммунные комплексы, при этом чужеродный антиген не обязательно должен быть инфекционной природы. Оно развивается и вокруг некротизированных тканей.
Среди физических причин воспаления наибольшее значение имеют лучевая и электрическая энергия, высокие и низкие температуры, вызывающие либо ожог тканей, либо их отморожение.
Воспаление является обязательным компонентом различных травм. Химическими факторами воспаления могут быть различные химические вещества, токсины и яды, в том числе образующиеся и в самом организме, например, при уремии (азотемии). Особенности воспаления существенно зависят и от структурно-функциональных особенностей органов и тканей. Таким образом, характер воспаления определяется сочетанием его причины, реактивности организма, в определенной степени зависящей от возраста и пола человека, а также структурно-функциональными особенностями тех органов или тканей, в которых оно развивается.
Местные реакции при воспалении
Воспаление - это сложный комплексный процесс, состоящий из трех взаимосвязанных реакций: альтерации (повреждения), экссудации и пролиферации, и в этом его уникальность как общепатологического явления. Лишь сочетание этих трех реакций позволяет говорить о воспалении. Если развивается только повреждение без экссудации и пролиферации, то это - некроз; экссудация без альтерации и пролиферации означает отек тканей; при пролиферации клеток без альтерации и экссудации, скорее всего, речь идет об опухолевом процессе. Воспаление как типовая патологическая реакция организма является патогенетическим звеном многих заболеваний. Вместе с тем оно может быть самостоятельной болезнью, требующей соответствующего лечения.
В основе процессов, составляющих воспаление, так же как и всех типовых патологических реакций, лежат физиологические механизмы. Так, физиологическая альтерация структур - необходимое условие функции, поскольку функция требует расходования структур клеток и тканей. Фагоцитоз как важнейший компонент воспаления в норме обеспечивает тканевой гомеостаз. Физиологические реакции гемокоагуляции, фибринолиза и транссудации являются основой воспалительной экссудации. Естественные процессы образования и созревания клеток - физиологический прототип пролиферативного компонента воспаления и репарации. Воспаление как комплексный процесс также имеет физиологический аналог - менструальный цикл, в динамике которого происходят альтерация, экссудация и пролиферация эндометрия. Этот процесс наряду с родами И.В. Давыдовский относил к дуалистическим процессам, имеющим все признаки болезни и вместе с тем, несомненно, физиологическим.
Воспаление, особенно в своем начале, наиболее ярко проявляется как местная реакция. Альтерация вызывает комплекс местных биохимических процессов, способствующих привлечению в очаг повреждения клеток - продуцентов медиаторов воспаления. Эти биологически активные вещества обеспечивают химические и молекулярные связи между реакциями, возникающими в очаге воспаления. Под влиянием медиаторов воспаления в зоне повреждения происходят биохимические и структурные преобразования тканей и их метаболизма, что обеспечивает развитие воспалительной реакции. Медиаторы воспаления могут быть клеточными (табл. 4.1) и плазменными (табл. 4.2). Клеточные медиаторы представлены в основном биогенными аминами, пептидами и белками, производными арахидоновой кислоты, активными радикалами кислорода, нуклеотидами и нуклеозидами. С клеточными медиаторами в первую очередь связаны фагоцитоз и повышение проницаемости микрососудов, они обладают также бактерицидным действием, разрушают ткани в области очага воспаления, вызывая вторичную альтерацию. Клеточные медиаторы включают иммунные механизмы в воспалительный процесс и, кроме того, регулируют пролиферацию и дифференцировку клеток при репарации поврежденных тканей.
| Вид медиатора | Источник | Эффекты |
|---|---|---|
Биогенные амины |
||
Гистамин |
Тучные клетки, базофилы, тромбоциты |
Боль, повышение сосудистой проницаемости, адгезивности эндотелия, секреции слизи, образования кининов, расширение артериол, стимуляция фагоцитоза |
Серотонин |
Тромбоциты, эозинофилы |
Повышение сосудистой проницаемости, агрегации тромбоцитов, боль, спазм поврежденных и расширение неповрежденных сосудов |
Адреналин, нор-адреналин |
Нейроны симпатической нервной системы, надпочечники |
Спазм сосудов, активация гликолиза, липолиза, перекисного окисления липидов, увеличение транспорта Са2+ в клетки, агрегация тромбоцитов |
Ацетилхолин |
Нейроны парасимпатической нервной системы |
Расширение микрососудов, стимуляция фагоцитоза, пролиферации и дифференцировки клеток |
Пептиды и белки |
||
ИЛ-1-4, 6, 8 |
Моноциты, макрофаги, лимфоциты, эндотелий |
Хемотаксис лейкоцитов, активация адгезивности эндотелия, лейкоцитоз, синтез белков острой фазы, пролиферация и дифференцировка лимфоцитов |
Интерфероны (ИФ) |
Моноциты, лимфоциты, макрофаги |
Активация макрофагов, NK-клеток, усиление экспрессии антигенов HLA, презентации антигенов, активация цитотоксичности, противовирусное действие |
Катионные белки |
Нейтрофилы, макрофаги |
Бактерицидный эффект, увеличение проницаемости сосудов, миграции лейкоцитов |
Гидролитические ферменты лизосом |
Собственные поврежденные клетки, фагоциты, микроорганизмы |
Увеличение проницаемости клеточных мембран, стенок сосудов, бактерицидное действие, разрушение коллагена, эластина, межклеточного вещества |
ФНО |
Макрофаги, лимфоциты, эндотелий |
Активация лейкоцитов, их адгезии, синтеза белков острой фазы, ангиогенеза, фиброгенеза, протеолиза, липолиза |
Производные арахидоновой кислоты |
||
Простагландины, фактор активации тромбоцитов (ФАТ) |
Синтез в мембранах лейкоцитов, тромбоцитов, тучных клеток, базофилов, эндотелия |
Простагландин Е2 - увеличение проницаемости сосудистой стенки, миграции лейкоцитов, расширение микрососудов, боль, лихорадка, дегрануляция тучных клеток, бронходилатация. Простагландин I2 (простациклин) - расширение микрососудов, стимуляция фибринолиза, снижение агрегации тромбоцитов. Простагландин F2α - спазм сосудов, бронхов, кишечника, подавление миграции лейкоцитов. Простагландин D2 - повышение проницаемости сосудистой стенки, расширение микрососудов. Тромбоксан А2 - спазм сосудов, бронхов, усиление хемотаксиса, миграции лейкоцитов, проницаемости сосудистой стенки, адгезивности эндотелия, агрегации и адгезии тромбоцитов. |
Лейкотриены |
Синтез под влиянием липооксигеназы в мембранах лейкоцитов, тромбоцитов, тучных клеток, базофилов, эндотелия |
В4 - усиление краевого стояния лейкоцитов, хемотаксиса, адгезии тромбоцитов. С4, D4, Е4 - повышение проницаемости сосудистой стенки, спазм сосудов, бронхов, кишечника |
Медиаторы плазменного происхождения представляют собой компоненты калликреин-кининовой системы, системы комплемента и системы гемостаза. Они повышают проницаемость микрососудов, активируют хемотаксис моноцитов и полиморфно-ядерных лейкоцитов, фагоцитоз и внутрисосудистую коагуляцию. Воспаление начинается с образования клеточных медиаторов, которые стимулируют сосудистую реакцию. В результате в процесс включаются плазменные медиаторы воспаления, функционирующие по каскадному принципу, активируя друг друга, и в очаг повреждения поступает экссудат, содержащий различные биологически активные вещества и клетки крови. Все эти реакции направлены на отграничение очага повреждения, фиксацию в нем и уничтожение повреждающего фактора.
| Вид медиатора | Источник | Эффекты |
|---|---|---|
Кинины (каллидин, брадикинин), калликреин |
Плазма крови и другие жидкости организма |
Увеличение проницаемости микрососудов, расширение артериол, активация фактора Хагемана, стимуляция хемотаксиса фагоцитов, боль, активация коллагеногенезы, циклооксигеназы |
Система комплемента |
Гепатоциты, моноциты, лейкоциты |
Активация фактора Хагемана, хемотаксиса и адгезии лейкоцитов, расширение капилляров, повышение проницаемости микрососудов, опсонизация, бактерицидность, цитолиз, стимуляция липоксигеназы, циклооксигеназы |
Система гемостаза |
Печень |
Активация кининов, повышение проницаемости микрососудов, образование тромбов, лизис свертка фибрина, усиление адгезии лейкоцитов, пролиферации фибробластов |
Вместе с тем на всех этапах воспаления идет высвобождение клеточных и гуморальных веществ, предупреждающих избыточное накопление и действие медиаторов. Это - антимедиаторы, их синтез происходит в макрофагах, тучных клетках, эозинофилах, базофилах, фибробластах (табл. 4.3). Соотношение медиаторов и антимедиаторов воспаления во многом определяет особенности развития воспалительного процесса.
| Вид антимедиатора | Эффекты |
|---|---|
Моноаминоксидаза |
Разрушение катехоламинов, серотонина |
Арилсульфатаза |
Расщепление лейкотриенов |
Гистаминаза |
Окислительное дезаминирование гистамина |
Антифосфолипаза |
Ингибирование синтеза медиаторов арахидонового каскада |
Антиоксиданты: пероксидаза; супероксид-дисмутаза; С-реактивный белок; церулоплазмин |
Инактивация кислородных радикалов, липоперекисей |
α-Антитрипсин, полиамины, гепарин, α2-макроглобулин |
Разрушение протеаз, комплемента, плазмина |
Глюкокортикоиды |
Широкое противовоспалительное действие |
Особенно многогранным противовоспалительным влиянием обладают глюкокортикоиды: они стимулируют продукцию антифосфолипаз, что ведет к угнетению фосфолипазы А2, уменьшают образование простагландинов (ПГ), лейкотриенов (ЛТ), фактора активации тромбоцитов (ФАТ), подавлению клеточной пролиферации и функции фибробластов. Они суживают микрососуды, что приводит к уменьшению экссудации жидкости, снижению хемотаксиса, активности фагоцитов и фибробластов, подавляют активность T- и B-лимфоцитов, образование ИЛ и других цитокинов.
Межклеточные взаимоотношения при воспалении
Динамическому процессу воспаления свойственны различные межклеточные и клеточно-матриксные взаимоотношения. Первыми в очаг повреждения и будущего воспаления приходят клетки - продуценты медиаторов воспаления: резидентные макрофаги, лаброциты, эозинофилы, NK-клетки и др. При включении в процесс микроциркуляторного русла в зону воспаления поступают полиморфно-ядерные лейкоциты. Их функция, помимо отграничения этой зоны, заключается в уничтожении патогенного фактора. Роль макрофагов более разнообразна: индукция иммунных реакций, отграничение очага воспаления, нейтрализация токсинов, регуляция разнообразных клеточных систем, участвующих в воспалении. При этом возникают межклеточные взаимодействия, прежде всего между макрофагами и полиморфно-ядерными лейкоцитами, лимфоцитами, моноцитами, фибробластами. Между всеми клетками экссудата, тканей и сосудов также происходят взаимодействия.
Так, макрофаги с помощью фагоцитоза помогают лейкоцитам очищать поле воспаления от патогенных раздражителей. Однако способность макрофагов убивать микроорганизмы менее выражена, чем у полиморфно-ядерных лейкоцитов, так как основной задачей макрофагов является фагоцитоз с целью выявления антигенных детерминант раздражителя и передача информации в иммунокомпетентную систему для последующего включения специфической (иммунной) защиты организма. Кроме того, система мононуклеарных фагоцитов осуществляет широкий комплекс процессов, формирующих воспаление. Взаимодействие макрофагов и лимфоцитов наиболее выражено при реакции гиперчувствительности замедленного типа (ГЗТ) в виде иммунного цитолиза и гранулематоза. Конечный результат этих реакций противоположен: иммунный цитолиз приводит к ликвидации патогенного фактора, а гранулематоз - к его сохранению при относительной изоляции от внутренней среды организма. Например, в туберкулезной гранулеме иммунные реакции направлены на уничтожение микобактерий, а незавершенный фагоцитоз - на сохранение возбудителей в эпителиоидных клетках. Это обеспечивает нестерильный иммунитет, в то же время гранулематозная реакция препятствует генерализации инфекции. Взаимодействие макрофагов и фибробластов направлено на стимуляцию коллагено- и фибриллогенеза путем воздействия моноцитов на функциональную активность клеток, синтезирующих коллаген и эластин. Эти взаимоотношения важны в репаративной фазе воспаления. Кроме того, макрофаги участвуют в местной и общей регуляции воспаления.
Таким образом, воспалительная реакция означает взаимодействие лимфоидных и нелимфоидных клеток, биологически активных веществ, множественные межклеточные и клеточно-матриксные взаимоотношения. В воспаление бывают вовлечены гормоны, Ig, нейропептиды, активирующие функции лейкоцитов и моноцитов через специфические рецепторы. Это подразумевает включение в процесс не только микроциркуляции, но и иммунной, эндокринной и нервной систем. Поэтому воспаление - это местное проявление общей реакции организма.
Воспаление как общепатологический процесс
В очаге воспаления возникает гамма чрезвычайно сложных процессов, дающих сигнал для включения различных систем организма. Материальные субстраты этих сигналов - накопление и циркуляция в крови биологически активных веществ, в том числе аутокоидов (метаболитов арахидоновой кислоты), кининов, компонентов комплемента, простагландинов, ИФ и др.
Среди факторов, связывающих местные и общие изменения при воспалении, большое значение имеют так называемые реактанты острой фазы. Эти вещества не специфичны для воспаления, они появляются через 4-6 ч после разнообразных повреждений тканей, в том числе при воспалении. Наибольшее значение из них имеют С-реактивный белок, ИЛ-1, α1-гликопротеид, T- кининоген, пептидогликаны, трансферрин, апоферритин и др. Большинство реактантов острой фазы синтезируют макрофаги, гепатоциты и другие клетки. ИЛ-1 влияет на функцию T- лимфоцитов в воспалительном очаге, активирует полиморфно-ядерные лейкоциты, стимулирует синтез простагландинов и простациклинов в эндотелиоцитах, способствует гемостазу в очаге повреждения и т. д. Концентрация С-реактивного белка при воспалении возрастает в 100-1000 раз. Этот белок активирует цитолитическую активность естественных T-лимфоцитов-киллеров, ингибирует агрегацию тромбоцитов. При воспалении отчетливо растет уровень T-кининогена - предшественника кининов и ингибитора α-цистеиновых протеиназ. Воспаление индуцирует синтез в печени апоферритина, стимулирующего выработку полиморфно-ядерными лейкоцитами супероксидных бактерицидных ионов. Реактанты острой фазы определяют неспецифический ответ организма, создающий условия для развития местной воспалительной реакции. Вместе с тем они способствуют включению в процесс других систем организма, взаимодействию местных и общих реакций при воспалении.
Особенности повреждающего фактора и величина очага повреждения также влияют на взаимосвязь местных и общих изменений при воспалительном процессе. Начиная с неких критических размеров очага повреждения, воспаление протекает с нарушениями гомеостаза, вызванными как продуктами повреждения тканей и медиаторами воспаления, так и стрессом (болевым, эмоциональным и др.). Включение в воспаление иммунной, нервной, эндокринной и других систем способствует образованию и накоплению специфических антител, реакциям клеточного иммунитета, стимуляции костного мозга, стрессорных механизмов, обусловленных болью, лихорадкой и т.п. Развитие общих признаков воспаления (лейкоцитоз, лихорадка, увеличение скорости оседания эритроцитов (СОЭ), диспротеинемия, изменение ферментного состава крови и системы гемостаза, интоксикация) - это реакция организма на местные изменения.
Воспаление обычно сопровождается интоксикацией, которая связана не только с самим воспалением, но и с особенностями повреждающего фактора, чаще всего инфекционного возбудителя. По мере увеличения площади повреждения и выраженности альтерации возрастает резорбция токсичных продуктов и интоксикация. Взаимоотношения интоксикации и воспаления весьма сложны. Интоксикация нарушает регуляцию многих процессов в организме и угнетает системы гомеостаза (иммунную, кроветворную и др.), что влияет на течение и характер воспаления. Очевидно, именно с тяжелой интоксикацией связана недостаточная эффективность воспаления как защитной реакции при сепсисе, остром разлитом перитоните, ожоговой и травматической болезнях, хронических инфекционных заболеваниях.
Таким образом, воспаление, начавшись как местная патологическая реакция, на определенном этапе развития обусловливает включение в процесс всех систем организма, составляя при этом основное звено патогенеза заболевания. Кроме того, как категория общей патологии воспаление имеет гомеостатический характер (сама альтерация тканей подразумевает возможность их будущей репарации после уничтожения и элиминации повреждающего фактора). Воспалительные заболевания могут привести к смерти или инвалидизации пациентов, но неизмеримо чаще заканчиваются выздоровлением. В этом случае организм человека нередко приобретает новые свойства, позволяющие ему эффективнее взаимодействовать с окружающей средой.
Классификация воспаления
В зависимости от преобладания в воспалительном процессе экссудации или пролиферации выделяют его клинико-анатомические формы - экссудативное или пролиферативное (продуктивное) воспаление. Раньше выделяли и альтеративное воспаление, но в связи с тем что при этом еще отсутствует сосудисто-мезенхимальная реакция, имеется только некроз ткани, а также в связи с краткосрочностью течения этой фазы процесса, в настоящее время альтеративное воспаление как самостоятельный вид не выделяют.
По течению воспаление может быть острым и хроническим. Оба варианта имеют различную морфологию и патогенетические механизмы. Острое воспаление протекает не более 4-6 нед, в большинстве случаев 1,5-2 нед. Если воспаление длится более 6 мес, его считают хроническим. В клинике иногда выделяют подострое воспаление, однако оно не имеет четкой морфологической специфики. Острое воспаление может быть как экссудативным, так и продуктивным (бешенство, сыпной и брюшной тиф и др.).
Острое воспаление
Стадии острого воспаления
Обычно трудно уловить грань между повреждением ткани и выделением определенными клетками медиаторов воспаления, т.е. началом воспалительной реакции. Однако без морфобиохимических изменений ткани, возникающих при ее повреждении, не может быть включена в процесс сосудистая реакция, возникающая после очень краткого латентного периода.
Стадия повреждения (альтерации)
Повреждение (альтерация) тканей и клеток - начальная, пусковая стадия воспаления, протекающая с выделением медиаторов воспаления. Эти изменения вызваны действием агрессоров и ответных защитных, преимущественно местных реакций организма. Различают биохимическую и морфологическую фазы альтерации.
Биохимическая фаза. Для нарушений метаболизма в зоне первичной альтерации, вызванной непосредственно повреждающим фактором, свойственно преобладание процессов катаболизма: протеолиза, липолиза, гликолиза. Это ведет к водно-электролитным расстройствам, изменению физико-химических параметров в очаге повреждения и развитию в нем ацидоза. Это в свою очередь обеспечивает активацию лизосомальных гидролаз, повреждающих клеточные и внеклеточные структуры, влияет на рецепторы сосудов, что нарушает регуляцию их тонуса и способствует сосудистым реакциям. Ацидоз, раздражая нервные окончания, вызывает боль.
Биохимические изменения приводят к образованию хемоаттрактантов - веществ, осуществляющих хемотаксис, т.е. направленное движение в очаг повреждения фагоцитов и клеток, продуцирующих медиаторы воспаления. К хемоаттрактантам относят Ig, C-реактивный белок, ИЛ-1, -8, ФНО-α, компоненты системы комплемента C5а, C3а, микроорганизмы, лейкотриен B4, тромбоксан A2, катионные белки, брадикинин, продукты деградации фибрина и коллагена, иммунные комплексы. По мере нарастания хемоаттракции кооперация клеток нарастает количественно и становится разнообразнее. Непосредственно после повреждения происходит выделение из тканей просеринэстеразы, тромбина, кинина и других хемоаттрактантов, а при повреждении сосудов - фибриногена и компонентов комплемента. Активация просеринэстеразы и подобных ферментов при любом повреждении клеток запускает серию молекулярных превращений, приводящих к выделению медиаторов воспаления. Важна также степень очаговой концентрации бактериальных хемоаттрактантов, не только привлекающих в зону повреждения клетки - продуценты медиаторов воспаления, но и вызывающих их деструкцию. В результате в очаг повреждения поступают клетки, продуцирующие медиаторы воспаления: лаброциты, базофильные и эозинофильные гранулоциты, моноциты, клетки APUD-системы, тромбоциты и др. Определенную роль в хемоаттракции играют резидентные макрофаги, продуцирующие цитокины.
Морфологическая фаза. Все эти клетки создают первичную клеточную кооперацию, знаменующую начало морфологической фазы воспаления. Для клеточной кооперации в очаге повреждения характерны ауторегуляторные механизмы, цикличность развития и разделение функций. Особое место в клеточной кооперации и во всем воспалительном процессе принадлежит макрофагам. Каждая из этих клеток содержит около 100 биологически активных веществ, участвующих в регуляции разнообразных процессов в организме. Одновременно макрофаги выступают как фагоциты, хотя фагоцитоз с целью уничтожения возбудителей - не основная задача макрофагов. Макрофаг - одна из главных антигенпредставляющих клеток.
Фагоцитируя повреждающие факторы, прежде всего биологической природы, макрофаги определяют их антигенные детерминанты, информация о них поступает в иммунную систему. Эти клетки в значительной степени регулируют воспаление, в том числе включение реактантов острой фазы и через них - всех систем организма в воспалительный процесс. Макрофаги участвуют в развитии пролиферации и репарации, образуя факторы роста и ангиогенеза. Вероятно, с ними связан нестерильный иммунитет, они обеспечивают апоптоз и множество других реакций организма. Резидентный макрофаг оказывает хемотаксическое действие, участвуя в создании первичной клеточной кооперации в очаге воспаления. Помимо этого, вырабатывая колониестимулирующий фактор, он усиливает образование и дифференцировку в костном мозге предшественников гранулоцитов. С помощью ИЛ-1, ИФ-α, цитокинов и факторов роста макрофаг стимулирует функции эндотелиоцитов и нейтрофильных гранулоцитов в очаге воспаления. Тем самым макрофаг, являясь клеткой местного воспалительного очага, способствует включению в процесс других систем организма. В образовании медиаторов велика роль лаброцитов, базофильных и нейтрофильных лейкоцитов.
В очаге повреждения все эти клетки обеспечивают выброс тканевых медиаторов, вызывая начало воспалительного процесса. Важнейшие из медиаторов - биогенные амины, прежде всего гистамин и серотонин. Гистамин вызывает острую дилатацию сосудов микроциркуляторного русла, что повышает сосудистую проницаемость и способствует отеку ткани, усиливает слизеобразование и сокращение гладкой мускулатуры. Серотонин также повышает сосудистую проницаемость и сокращение гладкомышечных клеток. Повреждение клеток вызывает выделение кислых липидов - источников таких медиаторов воспаления, как лейкотриены C4, D4, E4, эозинофильный хемотаксический фактор A, фактор активации тромбоцитов, простагландины, которые повреждают сосуды микроциркуляторного русла и повышают их проницаемость, а также способствуют пролиферации фибробластов. Кроме того, при повреждении сосудов происходит высвобождение вазоконстрикторных веществ, образованных тромбоцитами и эндотелием (эндотелина, катехоламинов, тромбоксана A2, простагландинов, лейкотриенов). При этом рефлекторно повышается тонус вазоконстрикторов и снижается активность вазодилататоров поврежденных сосудов. Поэтому первая реакция микроциркуляторных сосудов на действие медиаторов воспаления - спазм с замедлением кровотока и стазом эритроцитов в капиллярах, что направлено на локализацию зоны воспаления и повреждающего фактора. Это приводит к ишемии тканей, ослаблению тканевого дыхания в них, нарастанию гликолиза и ацидоза, активизации перекисного окисления липидов, приводящего к повреждению мембранных структур клеток. Все это усиливает повреждение тканей и образование медиаторов воспаления. В результате биохимических реакций в соединительной ткани очага воспаления повышается осмотическое давление, они набухают, и в них задерживается жидкость.
Накопление в зоне альтерации медиаторов воспаления, обладающих сосудорасширяющим действием (кининов, простагландина E2, аденозина, компонентов комплемента и др.), приводит к смене спазма сосудов микроциркуляции на артериальную гиперемию. Этому способствует и усиление парасимпатических нервных влияний вследствие увеличения высвобождения ацетилхолина из нервных окончаний. Кроме того, сосуды утрачивают способность реагировать на нервные и гуморальные влияния. Увеличивается выход плазмы крови из сосуда. При этом в результате действия тканевых медиаторов воспаления происходит первичная активация плазменных медиаторов воспаления - системы комплемента, плазмина и свертывающей системы крови, обеспечивающих развитие стадии экссудации.
Таким образом, в стадии альтерации возникают биохимические и морфологические процессы, приводящие к включению местных реакций в виде изменений микроциркуляции, развития некробиоза и некроза тканей в очаге повреждения, а также к вовлечению регуляторных систем всего организма. По этой причине стадия альтерации имеет важнейшее самостоятельное значение, без нее не возникнут экссудативная и некротическая реакции, определяющие характер и динамику всего воспаления, может запаздывать реакция иммунной системы, что имеет тяжелые последствия.
Стадия экссудации
Эта стадия связана с образованием экссудата - богатой белком жидкости, содержащей больше 2,5 г/л белка, форменные элементы крови, остатки распавшихся тканей и, нередко, возбудителей воспаления. Стадия экссудации возникает после повреждения клеток и тканей в ответ на действие вначале клеточных медиаторов воспаления, но особенно плазменных медиаторов, возникающих при активации трех систем крови - кининовой, комплементарной и системы гемостаза. Все компоненты этих систем существуют в крови в виде предшественников и начинают функционировать только после воздействия определенных активаторов. В плазме крови присутствует и система ингибиторов, уравновешивающих действие активаторов. Плазменные медиаторы кининовой системы - брадикинин и калликреин. Брадикинин усиливает сосудистую проницаемость, вызывает чувство боли, обладает выраженным гипотензивным действием. Калликреин осуществляет хемотаксис лейкоцитов, но главное его значение - активация фактора Хагемана, благодаря чему происходит включение в воспалительный процесс системы свертывания крови и фибринолиза. Фактор Хагемана инициирует свертывание крови, активирует плазменные медиаторы воспаления и сам выступает как медиатор, повышая проницаемость сосудов, усиливая миграцию нейтрофилов и агрегацию тромбоцитов. В результате система свертывания крови становится компонентом воспалительной реакции. Система комплемента состоит из специальных белков плазмы крови, вызывающих лизис бактерий и клеток, в том числе собственных тканей. Кроме того, ряд компонентов комплемента, прежде всего C3b и C5b, повышают проницаемость сосудов, усиливают хемотаксическую активность нейтрофилов и макрофагов. Комплексное действие клеточных и плазменных медиаторов воспаления, других продуктов, накапливающихся в зоне местного нарушения гомеостаза и вызывающих изменение проницаемости стенок микроциркуляторных сосудов, поступление в зону воспаления из крови клеточных элементов, приводят к развитию стадии экссудации. Эта стадия включает ряд этапов, приводящих к образованию экссудата:
Сосудистые реакции, возникающие при развитии воспаления, проявляются в расширении сосудов микроциркуляторного русла, усилении притока крови к очагу воспаления (активная гиперемия) при одновременном замедлении венозного оттока (пассивная гиперемия). Это связано с нарушением реологических свойств крови (сладж, микротромбоз), пристеночным стоянием лейкоцитов и повышением проницаемости сосудистой стенки. При этом появляются отек и набухание воспаленных тканей, в них скапливается экссудат. Кроме того, в процесс вовлекается лимфатическая система, развиваются лимфостаз и острый лимфатический отек, и отечные ткани сдавливают венулы. Все эти процессы обусловливают развитие гипоксии в зоне воспаления. Кроме того, прекращение кровотока способствует изоляции очага воспаления от окружающих тканей и уменьшению всасывания токсичных веществ из этой зоны.
Развитию собственно экссудации способствует ряд факторов, причем важнейший среди них - увеличение проницаемости сосудистой стенки под влиянием медиаторов воспаления, катионных белков и цитокинов. При этом в эндотелиоцитах резко возрастает микропиноцитоз и увеличивается трансэндотелиальный транспорт плазмы крови. Вместе с тем происходит разрушение гликозаминогликанов и белков базальной мембраны, а также повреждение эндотелия. Одновременно с этим начинается эмиграция лейкоцитов из сосудов в ткани, что приводит к образованию экссудата.
Эмиграция лейкоцитов и других форменных элементов крови. Механизм выхода лейкоцитов из сосудов также имеет несколько этапов: краевое стояние лейкоцитов, прохождение их через стенку микрососудов и поступление в очаг воспаления. Под влиянием медиаторов воспаления, хемотаксических факторов и замедления скорости кровотока происходит перемещение лейкоцитов из осевого цилиндра и приближение их к стенке сосудов. В нормальных условиях адгезии лейкоцитов к эндотелию мешает отрицательный заряд тех и других клеток и отталкивание их друг от друга. При развитии экссудации под влиянием медиаторов воспаления в процесс включаются катионы плазмы - Ca2+, Mn2+ и Mg2+, которые меняют отрицательный заряд эндотелия на положительный. В результате отрицательно заряженные лейкоциты притягиваются к сосудистой стенке. Кроме того, при экссудации лейкоциты должны перейти в активированное состояние, чтобы воспринимать сигналы хемоаттрактантов с помощью рецепторов (молекул адгезии), которые образуются на их цито- мембране под влиянием лейкотриена B4, ИЛ-1, -8, α-ИФ, ФНО-α, липополи-сахаридов оболочек бактерий. Адгезии лейкоцитов способствуют и фракции C5a, C1, C3 комплемента, и Fc-фрагменты IgG.
Эндотелиоциты при воспалении также экспрессируют молекулы клеточной адгезии, выделяют интегрины и межклеточные адгезивные молекулы (ICAM-1 и VCAV-1). При выраженной интоксикации и отложении в стенке сосудов иммунных комплексов или агрегированного Ig возможна дегрануляция полиморфно-ядерных лейкоцитов непосредственно в просвете сосуда и повреждение их гидролазами сосудистой стенки. Это усиливает выделение эндотелиоцитами биологически активных веществ и экссудацию.
Благодаря действию ферментов лейкоцитов на внутреннюю оболочку сосудов при их краевом стоянии происходит сокращение эндотелиальных клеток и раскрываются межэндотелиальные щели, к которым подходят нейтрофилы. Лейкоцит образует псевдоподию, входящую в межэндотелиальную щель и под эндотелиоцит. Затем туда перемещается весь лейкоцит, располагаясь между эндотелием и базальной мембраной сосуда (рис. 4.1 а). Молекулярные изменения базальной мембраны позволяют клеткам крови преодолевать ее и эмигрировать в зону воспаления. Этот механизм характерен для всех клеток крови, включая эритроциты (рис. 4.1 б, в).

При остром воспалении нейтрофильные лейкоциты выходят в воспалительный очаг в течение первых 6-24 ч. Через 24-48 ч преобладает эмиграция моноцитов и лимфоцитов. Порядок эмиграции клеток зависит в первую очередь от причины воспаления. Например, при бактериальных инфекциях первыми в воспаленные ткани поступают нейтрофильные лейкоциты, при вирусных заболеваниях и туберкулезе раньше других в зону воспаления мигрируют лимфоциты, при иммунном воспалении - эозинофилы. Лейкоциты, помимо фагоцитоза и уничтожения раздражителей, вызывают разрушение ткани с помощью гидролаз и токсических соединений кислорода, в результате чего образуется детрит.
Для клеточной кооперации, возникшей в очаге воспаления в результате альтерации тканей и экссудации, характерны ауторегуляторные механизмы и разделение функций между клетками. Основную защиту против микроорганизмов, особенно при гнойной инфекции, осуществляют нейтрофилы. Это «дежурные» клетки системы неспецифической резистентности организма. Их эмиграция происходит одновременно с сосудистой реакцией. Нейтрофилы первыми вступают в контакт с инфекционным возбудителем в очаге повреждения и блокируют его дальнейшее проникновение в организм. Они реагируют на любого возбудителя, уничтожая его с помощью фагоцитоза и экзоцитоза, и при этом погибают. Позднее к нейтрофильной инфильтрации присоединяются моноцитарная и макрофагальная, что характеризует начало отграничения воспаленной зоны за счет образования клеточного вала по ее периферии.
Важный компонент воспаления - развитие некроза тканей. Это выгодно для организма, поскольку в очаге некроза должен погибнуть патогенный фактор. Чем скорее разовьется некроз, тем меньше будет осложнений воспаления, а погибшая ткань затем регенерирует с восстановлением ее функции. Гибели ткани в очаге воспаления способствует образование клетками различных гидролаз и тромбоз мелких сосудов вокруг воспаленного участка. Это отграничивает воспаленную область и обусловливает развитие гипоксии тканей и их некроз. Поэтому в разгар экссудативной воспалительной реакции, когда все поле воспаления инфильтрировано лейкоцитами и концентрация гидролитических ферментов в нем, очевидно, очень высока, макрофаги практически не поступают в очаг воспаления, концентрируясь на его периферии. В противном случае они просто погибнут в центре очага воспаления, в то время как функция их значительно сложнее, нежели просто фагоцитоз возбудителя.
Как было указано выше, макрофаги играют особую роль в воспалении, выступая в качестве как местного регулятора воспаления, так и связующего звена между местными проявлениями этого процесса и общими реакциями на него организма. Кроме того, макрофаги важны как первое звено становления иммунитета при развитии воспаления. Задачи фагоцитоза, осуществляемого макрофагом, не только уничтожение инфекта для снижения его концентрации в очаге воспаления, но и выявление его антигенных детерминант и последующая передача информации об этом в иммунную систему. С этих позиций понятно, почему фагоцитарная активность макрофагов по отношению к бактериальной инфекции значительно ниже, чем нейтрофильных лейкоцитов. Понятно также, почему макрофаги не поступают в очаг гнойного воспаления в разгар экссудации и наиболее выраженной лейкоцитарной инфильтрации, а располагаются на периферии зоны воспаления, участвуя в формировании второго барьера, изолирующего воспаленные ткани. Эту целесообразность подтверждает и особенность патогенеза асептического воспаления, когда в очаге повреждения присутствуют не чужеродные, а измененные свои антигены. Через 18-24 ч лейкоциты покидают зону повреждения и только после этого ее заполняют макрофаги, не подвергаясь опасности лизиса под действием гидролаз нейтрофилов. Объяснимо и то, что при хроническом, особенно гранулематозном воспалении, когда антигенная структура возбудителя уже известна, для макрофагов часто характерен незавершенный фагоцитоз и то, что при стимуляции иммунной системы значительно возрастает количество макрофагов, участвующих в отграничении очага воспаления.
Таким образом, при воспалении местно возникают чрезвычайно сложные процессы, которые служат сигналом для включения в воспалительную реакцию различных систем организма, трансформируя местные изменения в реакцию всего организма.
Стадия пролиферации
Пролиферативная (продуктивная) стадия завершает воспаление. В этот период происходит уменьшение гиперемии воспаленной ткани, снижение интенсивности образования экссудата и эмиграции форменных элементов крови, особенно нейтрофилов. Для продуктивной стадии характерны анаболические процессы. Повышен синтез клеточных ферментов, в том числе гидролаз лизосом моноцитов, гистиоцитов, макрофагов, обеспечивающих «очищение» поля воспаления. После переваривания бактерий и ликвидации некротического детрита полиморфно-ядерные лейкоциты погибают. Постепенно очаг воспаления заполняют макрофаги гематогенного происхождения, T- и B-лимфоциты, плазмоциты, моноциты, т.е. клетки иммунной системы, а также тромбоциты, фибробласты. При этом они выделяют ИЛ, стимулирующие пролиферацию фибробластов и активирующие новообразование сосудов, эндотелий которых активно участвует в воспалительной пролиферации. Скопление клеток в очаге воспаления называют воспалительным инфильтратом.
Большинство клеток инфильтрата синтезирует медиаторы воспаления и различные факторы роста, которые стимулируют синтез ДНК в клетках, влияют на образование и активность ферментов и рецепторов, обеспечивающих процессы пролиферации. Таким образом, в основе восстановления (регенерации) поврежденной ткани или образования соединительной ткани лежит стимуляция продукции этих клеток. Если в цитоплазме клеток инфильтрата, между ними, в стенках мелких сосудов имеются различные Ig, возможно образование гранулем.
Процессы пролиферации имеют сложную регуляцию. Их активаторами являются антимедиаторы воспаления (глюкокортикоиды, антиоксиданты, ингибиторы гидролаз), факторы роста фибробластов, эпидермиса, нервов, ИЛ-1, 2-7, инсулиноподобный фактор роста, а ингибиторами - ФНО, кейлоны. Гормональная регуляция регенерации при воспалении происходит под действием соматотропина, инсулина, тироксина, обладающих прямым стимулирующим действием на пролиферацию различных клеток. Усиливают регенерацию и эндогенные опиаты. Постепенно происходит разрушение клеток инфильтрата, и в очаге воспаления начинают преобладать фибробласты, возникающие из местных камбиальных элементов. Они осуществляют фибриллогенез и превращаются в фиброциты. Повышен синтез ДНК и РНК, основного вещества. В динамике пролиферации возникает грануляционная ткань, заполняющая всю зону повреждения. Она обладает большой резорбционной способностью, но в то же время служит барьером для возбудителей воспаления, что было показано еще в конце XIX в., в том числе М.Н. Никифоровым (1895). Воспалительный процесс заканчивается созреванием грануляций и образованием зрелой соединительной ткани, масса ее различна и зависит от глубины повреждения. При субституции, что наиболее характерно для воспаления, грануляционная ткань созревает до соединительнотканного рубца. Если воспаление завершается реституцией, происходит восстановление исходной ткани, включая специфические особенности ее структуры.
КЛИНИКО-МОРФОЛОГИЧЕСКИЕ ФОРМЫ ВОСПАЛЕНИЯ
Экссудативное воспаление
В зависимости от причины воспаления и реакции организма на повреждающий фактор образуются различные воспалительные экссудаты, и в зависимости от особенностей экссудата острое экссудативное воспаление получает соответствующее название. В связи с этим экссудативное воспаление может быть серозным, фибринозным, гнойным и гнилостным. Кроме того, иногда к специфическому экссудату примешиваются кровь или слизь. Это не меняет вида воспаления, но указывает на то, что оно развивается на слизистых оболочках и в таком случае называется катаральным (катар). Если к тому или иному экссудату примешивается кровь, то воспаление называется геморрагическим. Встречается и смешанное воспаление, когда в силу определенных причин происходит смешение экссудатов. Катаральное, геморрагическое и смешанное воспаления не являются самостоятельными видами острого экссудативного воспаления, а являются лишь вариантами видов воспаления с характерным экссудатом.
Течение экссудативного воспаления обычно острое, но оно может протекать и хронически.
Исходом острого экссудативного воспаления наиболее часто является полное выздоровление с восстановлением исходной ткани (реституция). Значительно реже в результате экссудативного воспаления развивается рубцовая ткань.
Серозное воспаление
Серозное воспаление характеризуется образованием серозного экссудата, содержащего до 2,5% белка и умеренное количество клеточных элементов, в основном лимфоцитов и различных лейкоцитов, слущенных эпителиальных или мезотелиальных клеток. Соотношение альбуминов и глобулинов в экссудате - от 0,55:1 до 2,7:1, концентрация солей - 0,3-0,7%, pH 7-7,1. Оно возникает в слизистых, серозных и синовиальных оболочках, серозных полостях, коже, в капсулах клубочков почек, перисинусоидальных пространствах печени, серозных полостях, а также в строме паренхиматозных органов при выраженной интоксикации как проявление гиперреактивности организма (межуточное воспаление). Серозный экссудат помимо основного назначения смывает с воспаленной поверхности микроорганизмы и их токсины, а также химические вещества.
Причинами развития серозного воспаления чаще всего являются вирусы (грипп, герпес, вирусный гепатит, ветряная оспа и др.), некоторые бактерии, аллергены, физические и химические факторы (термические, лучевые, химические ожоги), экзогенные и эндогенные токсины, вызывающие выраженную плазморрагию.
Морфология. Воспаленные органы полнокровны. Экссудат в виде мутноватой жидкости с небольшим количеством клеточных элементов накапливается в серозных полостях, в мозговых оболочках при серозном менингите, при этом он может сдавливать мозг. Серозное пропитывание межальвеолярных перегородок в легких может быть причиной синдрома острой дыхательной недостаточности, а сдавливание легких при скоплении экссудата в плевральных полостях может сопровождаться ателектазом легочной ткани. Серозное воспаление кожи, например, при ожоге, сопровождается образованием пузырей, заполненных мутным экссудатом. При развитии серозного воспаления на слизистых оболочках к экссудату примешивается слизь, и в таком случае говорят о серозном катаре (рис. 4.2).

Клинически для серозного воспаления, как и любого другого экссудативного воспаления, характерны лихорадка, умеренный лейкоцитоз крови, повышение СОЭ и др.
Исход серозного воспаления обычно благоприятный - происходит рассасывание экссудата и завершение процесса путем реституции. Иногда после серозного воспаления паренхиматозных органов в них развивается диффузный склероз.
Фибринозное воспаление
Для этого вида воспаления характерно образование экссудата, содержащего помимо полиморфно-ядерных лейкоцитов, лимфоцитов, моноцитов, макрофагов, распадающихся клеток воспаленных тканей, большое количество фибрина, который образуется в некротизированной ткани под действием тромбопластина. Поэтому в фибринозном экссудате содержание белка выше, чем в серозном, и сам экссудат уплотняется.
Этиология фибринозного воспаления разнообразна: его вызывают микробы (дифтерийная коринебактерия, кокковая флора, возбудители дизентерии, микобактерия туберкулеза), вирусы, аллергические, экзогенные и эндогенные токсические факторы.
Морфология фибринозного воспаления. Оно развивается на слизистых или серозных оболочках. Экссудации предшествуют некроз тканей и агрегация тромбоцитов в очаге повреждения. Фибринозный экссудат пропитывает мертвые ткани, образуя светло-серую пленку, под ней располагаются микроорганизмы, выделяющие большое количество токсинов. Толщина пленки зависит от глубины некроза, структуры покровного эпителия, его связи с подлежащими тканями и особенностей их стромы. В зависимости от глубины некроза и толщины фибринозной пленки выделяют крупозное и дифтеритическое фибринозное воспаление.
Крупозное воспаление (от шотл. croup - пленка) развивается на слизистых или серозных оболочках, покрытых однослойным эпителием, расположенным на тонкой соединительнотканной основе. В этих условиях некроз не может быть глубоким, поэтому возникает тонкая фибринозная пленка, она легко отделяется сама или ее легко можно снять. При этом не образуется язвенная поверхность. Крупозное воспаление возникает на слизистых оболочках трахеи и бронхов, на серозных оболочках (фибринозный плеврит, перикардит, перитонит), при фибринозном альвеолите, крупозной пневмонии (рис. 4.3).

Дифтеритическое воспаление (от греч. diphteria - кожица) развивается на многослойном плоском неороговевающем эпителии, переходном или однослойном эпителии с рыхлой широкой соединительнотканной основой органа, что способствует развитию глубокого некроза и формированию толстой, трудно снимаемой фибринозной пленки, после ее удаления остаются глубокие язвы. Дифтеритическое воспаление возникает в ротоглотке, на слизистых оболочках пищевода, матки, влагалища, желудка, кишечника, мочевого пузыря, в ранах кожи и слизистых оболочек (рис. 4.4).
Исход фибринозного воспаления слизистых оболочек - аутолиз фибринозных пленок с помощью гидролаз полиморфно-ядерных лейкоцитов. Крупозное воспаление слизистых и серозных оболочек, как правило, заканчивается реституцией поврежденных тканей. Дифтеритическое воспаление протекает с образованием язв и последующей субституцией, при глубоких язвах возможно образование рубцов. Поскольку фибрин активирует фибробласты, нерастворенный фибринозный экссудат подвергается организации и замещению соединительной тканью. На серозных оболочках часто возникают спайки, шварты, нередко фибринозное воспаление оболочек полостей тела вызывает их облитерацию.

Гнойное воспаление
Для гнойного воспаления характерно образование гнойного экссудата, в котором содержится 3-8% белка. Это жидкая, сливкообразная масса, состоящая из плазмы крови, содержащей альбумины, глобулины, комплемент и другие биологически активные вещества, умеренное количество фибрина, клетки и детрит тканей очага воспаления, микроорганизмы, форменные элементы крови. Среди них преобладают живые и погибшие нейтрофильные лейкоциты (17-29%). Кроме того, в экссудате есть лимфоциты, макрофаги, часто эозинофильные гранулоциты. Гной имеет специфический запах, синевато-зеленоватую окраску различных оттенков, pH гноя 5,6-6,9.
Гнойный экссудат содержит различные ферменты, в первую очередь протеазы, способные расщеплять погибшие и дистрофически измененные структуры в очаге повреждения, в том числе коллагеновые и эластические волокна, поэтому для гнойного воспаления характерен лизис тканей. Наряду с полиморфно-ядерными лейкоцитами, способными фагоцитировать и убивать микроорганизмы, в экссудате присутствуют бактерицидные факторы (Ig, компоненты комплемента и др.). Бактерицидные факторы вырабатывают жизнеспособные лейкоциты, они также возникают при распаде погибших лейкоцитов и поступают в экссудат вместе с плазмой крови. В связи с этим гной задерживает рост бактерий и уничтожает их. Нейтрофильные лейкоциты гноя имеют разнообразную структуру в зависимости от времени поступления их из крови в зону нагноения. Через 8-12 ч полиморфно-ядерные лейкоциты в гное погибают и превращаются в гнойные тельца.
Этиология гнойного воспаления - гноеродные (пиогенные) стафилококки, стрептококки, гонококки, брюшнотифозная палочка и др. Гнойное воспаление возникает практически в любых тканях и органах. Течение его может быть острым и хроническим.
Морфология. Основные формы гнойного воспаления: абсцесс, флегмона, эмпиема, гнойная рана и ее разновидность - острые язвы.
Абсцесс - отграниченное гнойное воспаление с образованием полости, заполненной гнойным экссудатом. Он возникает в жизнеспособных тканях после сильного воздействия микроорганизмов или в погибших тканях, где нарастают процессы аутолиза.
Уже через несколько часов после начала гнойного воспаления вокруг скопления экссудата виден вал из клеток крови: моноцитов, макрофагов, лимфоцитов, эозинофилов, скоплений фибрина. При этом на фибрине происходит осаждение циркулирующих иммунных комплексов, которые являются хемоаттрактантами для комплемента, обладающего выраженными гистолитическими свойствами. Кроме того, комплемент - это хемоаттрактант для полиморфно-ядерных лейкоцитов, он стимулирует их эмиграцию из сосудов и поступление в очаг воспаления. Фибрин и комплемент - основа для формирования так называемой пиогенной мембраны, которая является внутренним слоем будущей соединительнотканной капсулы абсцесса. Разумеется, здесь не образуется гной, но из-за хемотаксиса лейкоциты поступают в очаг воспаления из сосудов и вначале концентрируются в области внутреннего слоя капсулы. Через 3-е суток вокруг абсцесса начинается формирование грануляционной ткани, которая созревает в соединительнотканную капсулу, имеющую 2 слоя: внутренний, обращенный в полость, состоящий из грануляций, фибрина, детрита, и наружный - из зрелой соединительной ткани. Через сосуды грануляционной ткани также происходит поступление в полость абсцесса лейкоцитов и частичное удаление из нее продуктов распада. На формирование капсулы абсцесса оказывает влияние состояние иммунитета - при иммунодефиците у пациента образуется неполноценная капсула, появляется склонность к расплавлению тканей, окружающих абсцесс, что является предпосылкой для развития флегмоны.
Исходом абсцесса обычно является спонтанное опорожнение и выход гноя на поверхность тела, в полости или полые органы. После прорыва абсцесса происходит его рубцевание. Если при сообщении абсцесса с поверхностью тела или какой-либо полостью нет спадения его стенок, возникает свищ - узкий канал, выстланный грануляционной тканью или эпителием. Изредка бывает инкапсуляция абсцесса и при этом происходит сгущение гноя. Иногда возможна петрификация абсцессов вокруг животных паразитов.
Флегмона - гнойное диффузное воспаление с пропитыванием и расслаиванием тканей гнойным экссудатом. Образование флегмоны зависит от патогенности возбудителя, состояния защитных систем организма, структурных особенностей тканей, где возникла флегмона и где есть условия для распространения гноя. Флегмона обычно возникает в подкожно-жировой клетчатке, межмышечных прослойках, стенке аппендикса, мозговых оболочках и т.п. (рис. 4.5). Флегмону волокнисто-жировой клетчатки называют целлюлитом.

Флегмона бывает двух видов:
Осложнения. В тех случаях, когда гнойное воспаление распространяется на артерии, возможен их тромбоз и при этом возникает некроз пораженных тканей, например гангренозный аппендицит. Нередко распространение гнойного воспаления на вены и лимфатические сосуды с развитием гнойных тромбофлебитов и лимфангитов. Флегмоны ряда локализаций под влиянием силы тяжести гноя могут стекать по ходу мышечно-сухожильньгх влагалищ, нервно-сосудистых пучков, жировых прослоек в нижележащие отделы, образуя там скопления, не заключенные в капсулу - так называемые «холодные абсцессы», или натечники. Чаще такое распространение гноя вызывает острое воспаление органов или полостей, например гнойный медиастинит - острое гнойное воспаление клетчатки средостения. Отторжение некротизированных и коагулированных тканей при твердой флегмоне может привести к кровотечению. Иногда возникают осложнения, связанные с тяжелой интоксикацией, всегда сопровождающей гнойное воспаление.
Исходы. Заживление флегмонозного воспаления начинается с его отграничения с образованием грубого рубца. Обычно флегмону удаляют хирургическим путем с последующим рубцеванием операционной раны. При неблагоприятном исходе возможна генерализация инфекции и развитие сепсиса.
Эмпиема - гнойное воспаление полостей тела или полых органов.
Причинами развития эмпием могут быть как гнойные очаги в соседних органах (например, абсцесс легкого и эмпиема плевральной полости), так и нарушение оттока гноя при гнойном воспалении полых органов (желчного пузыря, червеобразного отростка, маточной трубы и т. д.). При этом нарушены местные защитные механизмы (постоянное обновление содержимого полых органов, поддержание внутриполостного давления, что определяет кровообращение в стенке полого органа; синтез и секреция защитных веществ, включая секреторные Ig). При длительном течении гнойного воспаления происходит облитерация полых органов.
Гнойная рана - особая форма гнойного воспаления, возникающая вследствие нагноения травматической, в том числе хирургической раны, или при вскрытии во внешнюю среду очага гнойного воспаления с образованием раневой поверхности. Различают первичное и вторичное нагноение в ране. Первичное нагноение возникает непосредственно после травмы и травматического отека. Вторичное нагноение - рецидив гнойного воспаления.
Осложнения гнойной раны: флегмона, гнойно-резорбтивная лихорадка, сепсис.
Исходом гнойной раны является ее заживление вторичным натяжением с формированием рубца.
Острые язвы являются разновидностью гнойной раны и представляют собой дефект кожи или слизистой оболочки и подлежащих тканей с явлениями некроза и, обычно, гнойного воспаления. Наиболее часто они развиваются в ЖКТ, реже на поверхности тела. По происхождению выделяют первичные и вторичные.
Первичные острые язвы возникают на поверхности тела, в пищеводе или желудке при непосредственном действии на кожу или слизистую оболочку кислот, щелочей, микроорганизмов, возможны термические воздействия. Характерны гнойно-некротические изменения тканей, причем преобладание того или иного компонента зависит от этиологического фактора. Исходом таких язв обычно является заживление с образованием рубцов.
Вторичные острые язвы возникают при ишемии ЖКТ, при стрессе, эндокринопатиях, они могут быть медикаментозного происхождения и др.
Осложнениями острых язв могут быть аррозия сосуда с развитием, например, желудочного кровотечения, при стероидных язвах иногда возникает перфорация стенки полого органа.
Исходом вторичных острых язв обычно является заживление тканей.
Гнилостное (ихорозное) воспаление
Такое воспаление возникает при попадании гнилостной микрофлоры в очаг гнойного воспаления с выраженным некрозом тканей. Обычно оно бывает у ослабленных больных с обширными, длительно незаживающими ранами или хроническими абсцессами. При этом гнойный экссудат приобретает особо неприятный запах гниения.
Морфологически преобладает прогрессирующий некроз тканей без склонности к отграничению. Некротизированные ткани превращаются в зловонную массу. Сопутствует нарастающая интоксикация, которая и служит причиной смерти.
Дополнительные виды экссудативного воспаления
Не являются самостоятельными формами геморрагическое и катаральное воспаления.
Катаральное воспаление развивается на слизистых оболочках и при этом происходит примесь слизи к любому экссудату. Значение этого воспаления для организма зависит от его локализации и характера течения.
Этиология катарального воспаления - различные инфекции, аллергические раздражители, термические и химические факторы. При аллергических ринитах возможна примесь слизи к серозному экссудату. Нередко возникает гнойный катар слизистой оболочки трахеи и бронхов.
Исход. Острое катаральное воспаление протекает 2-3 нед, обычно не оставляя следов. При хроническом катаральном воспалении возможны атрофические или гипертрофические изменения слизистой оболочки.
Геморрагическое воспаление может быть разновидностью серозного, фибринозного или гнойного воспаления. Для него характерны высокая проницаемость микроциркуляторных сосудов, диапедез эритроцитов и примесь их к экссудату (серозно-геморрагическое, фибринозно-геморрагическое и гнойно-геморрагическое воспаление).
Этиология. Обычно геморрагическое воспаление возникает при выраженной интоксикации, особенно при вирусных инфекциях, в том числе при тяжелых формах гриппа, при чуме, сибирской язве, натуральной оспе. Оно ухудшает течение болезни. Если эритроциты распадаются в условиях доступа к ним воздуха, происходят соответствующие превращения гемоглобина, и экссудат приобретает черный цвет («черная оспа»). При гнойном воспалении возможна аррозия кровеносного сосуда и кровотечение, но это является осложнением гнойного воспаления, а не геморрагическим воспалением.
Исход геморрагического воспаления зависит от его этиологии.
Продуктивное (пролиферативное) воспаление
Это воспаление, при котором пролиферация клеточных элементов преобладает над альтерацией и экссудацией. Оно встречается в любом органе или ткани. В результате пролиферации клеток образуются очаговые или диффузные скопления (пролифераты) из лимфоцитов, плазмоцитов, моноцитов, макрофагов, гигантских или эпителиоидных клеток и др. В большинстве случаев этому способствует особая реактивность организма. Кроме того, сам этиологический фактор обусловливает пролиферативную клеточную реакцию, что особенно типично для вирусов и риккетсий, но и некоторые бактерии могут быть причиной этого.
Выделяют следующие виды продуктивного воспаления:
Упоминающиеся иногда в учебниках воспалительные гиперпластические разрастания в виде полипов и остроконечных кондилом по существу не являются продуктивным воспалением, а представляют собой гиперрегенераторную реакцию эпителия на хроническое экссудативное (катаральное или гнойное) воспаление.
Продуктивное воспаление может протекать остро и хронически. Исходом продуктивного воспаления чаще является образование рубцовой ткани в области бывшего воспалительного процесса.
Интерстициальное (межуточное) диффузное воспаление
Интерстициальное (межуточное) диффузное воспаление может быть вызвано различными инфекционными агентами или развивается как реакция активной мезенхимы органов на выраженные токсические воздействия, в том числе микробную интоксикацию. В этом случае оно чаще имеет острое течение. Продуктивное воспаление возникает в строме всех паренхиматозных органов и проявляется образованием инфильтратов из воспалительных и иммунокомпетентных клеток. Очень важно, что в строме органов проходят сосуды микроциркуляторного русла, несущие кровь к клеткам паренхимы, здесь же локализуются нервные окончания, в строме располагаются и лимфатические капилляры. Все эти структуры осуществляют трофику паренхиматозных клеток. Поэтому при воспалении в строме нарушается метаболизм и паренхиматозных элементов сердца, печени, почек, легких. В них развиваются дистрофические, иногда некробиотические изменения и страдают функции этих органов.
Наиболее яркая картина интерстициального продуктивного воспаления развивается при интерстициальном миокардите, интерстициальном гепатите, интерстициальном нефрите, острой и хронической интерстициальной пневмонии.
Интерстициальный, или межуточный, миокардит чаще возникает при инфекционном или токсическом воздействии. Выделяют преимущественно экссудативные и преимущественно продуктивные формы интерстициального миокардита (рис. 4.6). При продуктивном миокардите в строме миокарда виден лимфогистиоцитарный и моноцитарный инфильтрат. К межуточным миокардитам относят, например, миокардит Абрамова-Фидлера, имеющий аллергическую природу.
Интерстициальный нефрит часто возникает при нарушении оттока мочи из почечной лоханки и развитии острого пиелонефрита, а также при различных инфекциях, интоксикациях, длительном приеме препаратов фенацетинового ряда и др. При остром интерстициальном нефрите в строме почек наблюдаются отек и инфильтрация лимфоцитами, плазмоцитами, нередко эозинофилами, а также макрофагами. Как правило, при этом возникают дистрофические и некротические изменения канальцев (тубулоинтерстициальный нефрит). При хроническом течении заболевания развиваются лимфоидная инфильтрация и фиброз межуточной ткани, особенно периваскулярный и перидуктальный. В канальцах наряду с дистрофическими и некротическими изменениями происходит регенерация эпителия.

Острое интерстициальное воспаление печени ведет к появлению в портальных трактах обычно серозного мононуклеарного инфильтрата, иногда с небольшим количеством полиморфно-ядерных лейкоцитов, всегда в сочетании с дистрофией паренхимы. Возможна трансформация острого межуточного гепатита различной этиологии в хронический гепатит, который характеризуется лимфомакрофагальной инфильтрацией стромы, деструкцией паренхиматозных элементов и склерозом портальных трактов.
Интерстициальная пневмония. Этиологическими факторами интерстициальных пневмоний являются вирусы, риккетсии и микоплазмы. В остром периоде заболевания наблюдаются отек интерстициальной ткани и инфильтрация ее клетками гематогенного происхождения.
Продуктивным компонентом воспаления являются поврежденные пневмоциты II типа, альвеолярные макрофаги, септальные клетки, эндотелиоциты. Фиброзирующий альвеолит (хроническая интерстициальная пневмония) не всегда имеет отчетливую этиологию, но в ряде случаев может быть вызван токсичными веществами или лекарственными препаратами. При этом в ответ на повреждение клеточных и внеклеточных структур межальвеолярных перегородок возникают пролиферация эндотелиоцитов и пневмоцитов II типа, инфильтрация интерстиция гематогенными воспалительными и иммунокомпетентными клетками, там же накапливаются фибробласты, и в итоге развивается септо-альвеолярный склероз.
Гранулематозное воспаление
Гранулематозное воспаление характеризуется образованием гранулем (узелков), возникающих в результате пролиферации и трансформации различных фагоцитов. Морфогенез гранулем складывается из 4 стадий.
-
Трансформация макрофагов в эпителиоидные клетки с образованием эпителиоидно-клеточной гранулемы.
-
Вероятно, слияние эпителиоидных клеток или макрофагов с трансформацией их в различные гигантские клетки (клетки Пирогова-Лангханса, клетки инородных тел) и формированием гигантоклеточных гранулем. Образование гранулемы может остановиться на любом этапе их морфогенеза. Таким образом, различают макрофагальную (простая гранулема или фагоцитома), эпителиоидно-клеточную и гигантоклеточную гранулемы. Диаметр гранулем не превышает 1-2 мм, поэтому они видны в основном под микроскопом.
Кроме того, некоторые гранулемы характеризуются низким уровнем метаболизма (обычно гранулемы вокруг инородных тел - частичек кремния, асбеста и т.п.), другие, в основном образующиеся при действии микробных раздражителей (микобактерий туберкулеза, лепры и др.) - высоким уровнем обмена веществ.
Этиология гранулем разнообразна. Выделяют инфекционные, неинфекционные и криптогенные (неизвестной этиологии) гранулемы. Инфекционные гранулемы могут быть острыми и хроническими. Острые инфекционные гранулемы развиваются при острых инфекционных заболеваниях - сыпном и брюшном тифе, бешенстве, эпидемическом энцефалите, остром переднем полиомиелите и др. Хронические инфекционные гранулемы развиваются при туберкулезе, лепре, сифилисе, склероме, сапе и др. Неинфекционные гранулемы встречаются при пылевых болезнях (пневмокониозах) - силикозе, талькозе, асбестозе и др.; в результате действия некоторых медикаментов. К гранулемам неустановленной этиологии относят гранулемы при саркоидозе, болезни Крона, гранулематозе Вегенера и др.
Патогенез различных гранулем неоднозначен, но есть два непременных условия для их развития: наличие раздражителя, способного стимулировать систему моноцитарных фагоцитов с образованием макрофагов, и устойчивость этого раздражителя по отношению к фагоцитозу. При этом в образовании и патогенезе инфекционных гранулем принимает участие иммунная система и поэтому такие гранулемы называются иммунными.
При сыпном тифе острые гранулемы возникают в тканях под влиянием токсинов риккетсий, поражающих эндотелий микрососудов. Риккетсии обладают тропизмом к эндотелиальным клеткам, проникают в них путем эндоцитоза, размножаются в цитоплазме и разрушают клетки. В результате сначала возникает фибриноидный некроз стенки сосуда, затем васкулит с инфильтрацией сосуда лимфоцитами, моноцитами, периваскулярно возникает скопление из перицитов, макрофагов, лимфоцитов, единичных нейтрофильных лейкоцитов. Появляется гранулема, в которой сосуд уже не определяется. Как правило, сыпнотифозные гранулемы обнаруживаются в центральной и периферической нервной системе, где определяются некрозы групп нейронов или ганглиозных клеток. В их основе лежат мелкоочаговые некрозы серого вещества головного или спинного мозга, окруженные глиальными элементами с функцией фагоцитов. Клетки глии резорбируют некротизированную ткань, после чего участвуют в образовании глиальных рубцов в ЦНС.
При бешенстве и ряде других нейроинфекций головного и спинного мозга возникают очаговые некрозы серого и белого вещества, патогенетической основой которых чаще всего являются воспалительные поражения стенок микроциркуляторных сосудов инфекционными агентами или их токсинами. Вокруг гиперемированных венул и капилляров образуются лимфоидные и моноцитарные инфильтраты. Нервные клетки, располагающиеся вблизи этих сосудов, подвергаются дистрофии и некрозу с развитием вокруг них пролиферации элементов микроглии. При выздоровлении в области гранулем возникают глиальные рубчики. Исход заболевания нередко зависит от локализации и объема рубцов.
При брюшном тифе гранулемы возникают в лимфоидных образованиях (солитарных фолликулах) тонкой кишки и выглядят как скопления фагоцитов, трансформированных из ретикулярных клеток («тифозные» клетки). Эти крупные округлые клетки со светлой цитоплазмой фагоцитируют S. typhi, а также детрит, образовавшийся в солитарных фолликулах. Тифозные гранулемы подвергаются некрозу, что связывают с токсинами сальмонелл, фагоцитированных брюшнотифозными клетками. При выздоровлении острые брюшнотифозные гранулемы исчезают бесследно, возникает реституция стенки кишки.
ХРОНИЧЕСКОЕ ВОСПАЛЕНИЕ
Как было указано выше, биологический смысл воспаления заключается в отграничении, уничтожении и элиминации патогенного фактора, после чего воспаление заканчивается репарацией и восстановлением гомеостаза. Однако нередко возникает ситуация, когда в силу различных причин патогенный раздражитель не подвергается уничтожению, и воспаление приобретает хроническое течение. Таким образом, хроническое воспаление - это патологический процесс, характеризующийся персистенцией патологического фактора. Наиболее часто (хотя и не всегда) при этом развивается иммунологическая недостаточность, что вызывает своеобразие морфологических изменений тканей в области воспаления, течение процесса по принципу порочного круга, нарушение репарации и восстановления гомеостаза. По существу хроническое воспаление - это проявление возникшего дефекта в системе защиты и приспособления организма к изменившимся условиям существования. Следует заметить, что современный этап учения о воспалении характеризуется еще недостаточными знаниями о природе хронического воспаления.
Этиология
Этиология хронического воспаления многообразна. Однако основная причина - персистенция повреждающего фактора, связанная как с его особенностями, так и с недостаточной воспалительной реакцией самого организма. Так, патогенный фактор может иметь высокую иммуногенность, повышенную стойкость к гидролазам лейкоцитов и макрофагов; завершению воспаления препятствует также большой объем раздражителя (например, эхинококка). Дефекты в защите самого организма могут быть обусловлены нарушением образования мононуклеарных фагоцитов и макрофагов, врожденной патологией лейкоцитов, в первую очередь нейтрофильных, ингибированием хемотаксиса, нарушением иннервации тканей в области воспаления, аутоиммунизацией этих тканей, генетическим повышением чувствительности к действию патогенного фактора и др.
Поскольку воспаление и иммунная система тесно связаны, то, естественно, иммунные механизмы играют основную роль и в патогенезе хронического воспаления. В длительно текущем воспалительном процессе участвуют все системы организма, о чем можно судить по изменениям крови и показателям иммунитета. Так, у пациентов, страдающих хроническими воспалительными заболеваниями, особенно хроническими ранами, пролежнями, как правило, возникают лимфоцитопения, снижение уровня всех T-лимфоцитов, в том числе T-хелперов и T-супрессоров, нарушение их соотношения, что указывает на развитие вторичного иммунного дефицита.
Повышено образование антител, особенно IgA и IgG. У большинства пациентов в крови отчетливо увеличен уровень циркулирующих иммунных комплексов (ЦИК), что связано не только с их повышенным образованием, но и с нарушением элиминации таких комплексов. Одновременно падает способность нейтрофилов к хемотаксису, что связано с накоплением в крови ингибиторов этого процесса (продуктов распада клеток, микроорганизмов, токсинов, иммунных комплексов), особенно при обострении воспаления.
Хроническое воспаление имеет особенности, зависящие от этиологии процесса, структуры и функции пораженного органа, реактивности организма и других факторов. Основное значение, очевидно, имеет персистенция раздражителя. Постоянная антигенная стимуляция иммунной системы, интоксикация, вызванная раздражителем, другими микроорганизмами и постоянным некротизированием тканей в очаге воспаления не только повышают функциональную нагрузку на иммунную систему, но и повреждают ее. При этом хроническая интоксикация нарушает как центральную, так и местную регуляцию воспалительного процесса. Не исключено, что в этих условиях образующаяся грануляционная ткань может приобретать аутоантигенные свойства, становясь дополнительным постоянным стимулом гиперфункции иммунной системы. Длительное напряжение последней через какое-то время приводит к срыву ее функций. Возникают патологические изменения, отражающие выраженную дисфункцию иммунной системы, постепенно нарастающий иммунный дефицит. Вместе с тем снижение бактерицидной и фагоцитарной функции лейкоцитов наряду с угнетением их хемотаксиса нарушает фагоцитоз, что способствует персистенции инфекции. Возникает порочный круг. При сохранении причин и условий течения хронического воспаления невозможны полноценная репарация очага воспаления и восстановление гомеостаза.
Морфология
Общий морфогенетический признак хронического воспаления - нарушение циклического течения процесса в виде постоянного наслаивания стадий альтерации и экссудации на стадию пролиферации. Это ведет к повторяющимся рецидивам воспаления и невозможности репарации. Грануляционная ткань при хроническом воспалении имеет особенности образования и созревания. Для нее характерны постоянно возникающие очаговые некрозы, лимфоплазмоцитарный инфильтрат со сниженным количеством полиморфно-ядерных лейкоцитов, макрофагов и относительно небольшим количеством активных фибробластов. В стенках сосудов и периваскулярной грануляционной ткани выявляют ЦИК, Ig, комплемент.
Наблюдают развитие продуктивных васкулитов, пролиферацию эндотелия в более крупных сосудах, вплоть до облитерации их просветов (рис. 4.7). При обострении заболевания васкулиты приобретают гнойный характер, в них нарастает деструкция эндотелия и падает пиноцитоз (рис. 4.8).

Количество капилляров обычно снижено, что усиливает гипоксию грануляционной ткани и нарушения метаболизма в ней. При этом страдают эндотелиоциты - секреторные клетки, участвующие в межклеточных взаимоотношениях. Они синтезируют ряд медиаторов воспаления и иммунитета, в том числе ИЛ-1, являющийся одним из медиаторов воспаления, реактантов острой фазы и одновременно усиливающий пролиферацию фибробластов и синтез ими коллагена. Повреждение эндотелия сосудов грануляционной ткани способствует нарушению ее созревания и межклеточной регуляции. В течение длительного времени грануляционная ткань остается на стадии рыхлой соединительной ткани, в ней преобладает нестойкий коллаген III типа, нарушено образование эластических волокон. Эти изменения усугубляет гипоксия, нарастающая по мере уменьшения количества измененных сосудов. Снижение парциального напряжения кислорода в ткани также нарушает функции фибробластов, в том числе синтез ими коллагена и эластина. Дефектные эластические волокна, играющие большую роль в репарации, образуют бесформенные скопления, что не позволяет им выполнять свои функции. Уменьшение количества коллагена I типа в очаге воспаления затрудняет эпителизацию гранулирующей раны.
Условия развития хронического воспаления.
Учитывая указанные особенности хронического воспаления, лечение таких больных должно быть направлено не только на борьбу с инфекцией и уничтожение персистирующего повреждающего фактора, но и на восстановление функции иммунной системы.
Выделяют хроническое экссудативное и продуктивное воспаление.
Хроническое экссудативное воспаление
Для этого воспаления характерно наличие умеренного количества экссудата, чаще гнойного, нередко гнойно-фибринозного. Преимущественно лимфоплазмоцитарная инфильтрация воспаленных тканей, но в инфильтрате присутствуют также нейтрофильные лейкоциты, а по периферии зоны воспаления - моноциты, макрофаги и фибробласты. Вокруг хронического абсцесса, очага остеомиелита возникает соединительнотканная капсула. При хроническом гнойном сальпингите полость маточной трубы заполнена гноем, стенка ее склерозирована, инфильтрирована лейкоцитами. Такой процесс может быть причиной развития пельвиоперитонита или абсцессов яичника и тканей малого таза. В хроническом абсцессе, при остеомиелите нередко возникают свищи, соединяющие очаг воспаления с какой-либо полостью или открывающиеся наружу. Через них гнойный экссудат покидает зону воспаления. После заживления такого воспаления образуется рубец.
Трофические язвы, обычно нижних конечностей, возникают при хроническом прогрессирующем нарушении кровообращения в результате склероза микроциркуляторных сосудов при сахарном диабете, нарушения трофики тканей при декомпенсированном варикозном расширении вен, иногда при атеросклерозе. Нарушению кровообращения сопутствуют нарушения лимфообращения и развитие лимфостаза, что наряду с гипоксией стимулирует фибробласты.
При пролежнях преобладает нарушение нервной трофики и вторичное нарушение кровоснабжения тканей. Для трофических язв и пролежней характерно развитие несозревающей грануляционной ткани. Указанные общие и местные биохимические и иммунологические изменения при трофических язвах и пролежнях объясняют низкую эффективность трансплантации кожи при этой патологии.
Морфология и патогенез язвенной болезни и неспецифического язвенного колита описаны в главе 13. Общие и местные факторы, поддерживающие хроническое воспаление в желудке и кишечнике, постоянно стимулируют фибробласты и выраженное развитие склеротических изменений в области воспаления, в том числе склероз артерий со стенозированием их просвета. Это приводит к прогрессирующему ухудшению кровоснабжения области воспаления, нарастанию гипоксии, которая, в свою очередь, препятствует развитию продуктивной фазы воспаления и также стимулирует фибробласты. Все это способствует выраженному склерозированию стенки желудка и приводит к стенозированию просвета кишки.
Хроническое продуктивное воспаление
Примерами хронического продуктивного диффузного воспаления могут быть интерстициальная пневмония и хронический гепатит (см. гл. 11 и 13). Часто их причиной служат вирусы, вначале вызывающие серозное воспаление, а затем преобладание продуктивного компонента воспалительного процесса. Характерно развитие пато- и морфогенеза по принципу порочного круга, прогрессирование продуктивных воспалительных реакций. В исходе развивается септоальвеолярный склероз легочной ткани или ЦП.
Гранулематозное воспаление
Классификация гранулематозного воспаления распространяется и на хронические гранулемы. Кроме того, выделяют специфические хронические гранулемы (туберкулез, сифилис, лепра, склерома), отражающие особенности заболевания, и неспецифические хронические гранулемы, возникающие при инфекционных заболеваниях (эхинококкоз, альвеолококкоз, бруцеллез и т.п.) или попадании в организм инородных тел и не имеющие характерных этиологических признаков.
Специфические иммунные гранулемы имеют наибольшее эпидемиологическое и диагностическое значение. Их функция - фиксация возбудителей в одном месте для предотвращения микробной генерализации и, очевидно, стимуляция иммунной системы. В патогенезе и морфогенезе этих гранулем особую роль играют эпителиоидные клетки. Заболевания с образованием эпителиоидных клеток и эпителиоидно-клеточных гранулем обладают нестерильным иммунитетом, т.е. возникший иммунитет сохраняется до тех пор, пока в организме персистирует возбудитель. Эту персистенцию и позволяет осуществить эпителиоидная клетка. Трансформация макрофага в эпителиоидную клетку происходит когда благодаря завершенному фагоцитозу становятся известны антигенные детерминанты возбудителя и возникают специфические иммунные реакции. После этого необходимы клетки, сохраняющие способность к фагоцитозу, но не способные завершить этот фагоцитоз. Такими клетками и являются эпителиоидные клетки. Они не образуют фагоцитарной вакуоли и почти полностью лишены лизосом, бактерицидная активность их очень низкая. Благодаря этому в них происходит эндоцитобиоз, в результате чего живые возбудители постоянно стимулируют иммунную систему, поддерживая нестерильный иммунитет. Кроме того, сами эпителиоидные клетки способны стимулировать иммунитет, синтезируя ИЛ-1, фактор роста фибробластов (ФРФ) и трансформирующий фактор роста (ТФР).
Полагают, что трансформация эпителиоидных клеток в гигантские возможна либо путем деления ядер при сохранении цитоплазмы, либо при слиянии цитоплазмы нескольких эпителиоидных клеток в одну гигантскую с множеством ядер. Гигантские клетки отличаются друг от друга количеством и расположением ядер: в гигантских клетках Пирогова-Лангханса до 20 ядер, расположенных по периферии клетки в виде подковы, а в гигантских клетках инородных тел - до 100 ядер, беспорядочно расположенных в центре клетки. В гигантских клетках обоих типов очень мало лизосом, вероятно, клетки обладают избирательным фагоцитозом и эндоцитобиозом. Клеточный состав специфических гранулем принципиально одинаков, однако соотношение клеток и их расположение в гранулеме зависят от причины заболевания. В центре специфических гранулем имеет место первичный или вторичный некроз ткани, который при некоторых заболеваниях (лепра, склерома) сменяется развитием абсцесса.
Туберкулезная гранулема
Туберкулезная гранулема имеет характерное строение. В центре ее зона казеозного некроза, окруженного эпителиоидными клетками, расположенными в виде частокола. Такую гранулему называют эпителиоидно-клеточной. За эпителиоидными клетками формируется вал из макрофагов сенсибилизированных T-лимфоцитов. Между эпителиоидными и лимфоидными клетками имеются 1-3 гигантские клетки Пирогова-Лангханса. Ограничивают гранулему фибробласты, расположенные за валом лимфоцитов (рис. 4.9).

При окраске по Цилю-Нильсену в эпителиоидных и гигантских клетках часто выявляют фагоцитированные микобактерии, а при импрегнации солями серебра в гранулеме видна тонкая сеть аргирофильных волокон. Сосудов в туберкулезной гранулеме нет, поэтому в ней отсутствуют лейкоциты. Лишь в наружных зонах бугорка видны мелкие сосуды. При благоприятном течении заболевания происходят фиброз и петрификация гранулемы, однако и в петрификатах сохраняются микобактерии, что обеспечивает нестерильный иммунитет.
Сифилитическая гранулема
Сифилитическая гранулема (гумма) образуется в третичном периоде сифилиса. Она, так же как и туберкулезная гранулема, является выражением нестерильного иммунитета. Гумма содержит зону коагуляционного некроза, имеющего клейкую консистенцию. Некроз окружают нейтрофильные лейкоциты, лимфоциты, плазматические клетки, фибробласты, макрофаги, а также умеренное количество эпителиоидных клеток и гигантских клеток типа Пирогова-Лангханса. В зоне некроза разрушается эластика. Вокруг гранулемы интенсивно развивается соединительная ткань, образуя капсулу. Около капсулы в воспалительном инфильтрате много мелких сосудов с явлениями продуктивного эндоваскулита. Причиной этого является инкубация в сосудах бледных спирохет, поэтому микроорганизмы оказывают влияние прежде всего на внутреннюю оболочку сосудов (рис. 4.10).

Помимо гумм для третичного сифилиса характерно развитие гуммозной инфильтрации, чаще всего в средней оболочке восходящей части и дуги аорты. Состав инфильтрата такой же, как в гумме, в нем много мелких сосудов типа vasa vasorum с явлениями васкулита, однако вокруг инфильтрата не возникает капсула. Развивается сифилитический мезаортит (рис. 4.11). Некроз в стенке аорты вызывает разрушение эластики и разрастание грануляционной ткани, которая, созревая, превращается в грубую соединительную ткань. В результате происходит неравномерное склерозирование стенки аорты, ее внутренняя оболочка становится неровной, морщинистой, бугристой и носит название «шагреневой кожи».

Осложнением сифилитического мезаортита является образование аневризмы восходящей части и дуги аорты, ее разрыв приводит к внезапной смерти. Значение гуммы зависит от ее локализации (в головном или спинном мозге, печени и т.д.).
Исход гуммы. При лечении возможно заживление очага воспаления с образованием грубых рубцов звездчатой формы. Гуммозные деструктивные поражения рото- и носоглотки приводят к нарушениям речи, глотания, дыхания, деформируют лицо, разрушая нос и твердое нёбо. При этом практичски исчезает иммунитет, что создает возможность повторного заражения сифилисом.
Лепрозная гранулема
Лепрозная гранулема (лепрома) имеет принципиально тот же клеточный состав инфильтрата, что и другие специфические гранулемы: макрофаги, эпителиоидные клетки, лимфоциты, плазматические клетки, фибробласты. Макрофаги содержат микобактерии лепры, расположенные параллельно в виде сигарет в пачке. Такие гигантские клетки называют лепрозными клетками Вирхова, и они, очевидно, являются аналогами эпителиоидных клеток (рис. 4.12).

Микобактерии лепры разрушают эти клетки и выпадают в клеточный инфильтрат лепромы, вероятно, стимулируя при этом иммунную систему. Среди макрофагов располагаются крупные клетки с большими жировыми включениями («лепрозные шары»). Полагают, что это погибшие макрофаги, в цитоплазме которых содержатся остатки разрушенных микобактерий и отработанные продукты метаболизма. После разрушения этих клеток содержавшиеся в них включения фагоцитируют гигантские клетки. Такая гранулема более характерна для лепрозной формы лепры, когда гранулематозное воспаление в основном поражает кожу и периферические нервы. Однако отдельные гранулемы обнаруживают почти во всех внутренних органах.
Для туберкулоидной формы лепры характерно развитие ГЗТ с образованием эпителиоидно-клеточных гранулем. В них выявляют микобактерии лепры, хотя и в меньшем количестве, чем при лепрозной форме болезни (см. гл. 17).
Склеромная гранулема
Склеромная гранулема представляет своеобразную грануляционную ткань со скоплением макрофагов, Т-лимфоцитов, а также плазматических клеток и продуктов деградации антител - эозинофильных телец Русселя. Макрофаги захватывают диплобациллы Волковича-Фриша, переваривают часть из них, выявляя антигенные детерминанты возбудителя. Затем они трансформируются в крупные клетки Микулича, в которых содержатся диплобациллы, но фагоцитоз в них незавершенный (эндоцитобиоз). Вероятно, клетки Микулича можно рассматривать как своеобразный аналог эпителиоидных клеток. При разрушении этих клеток возбудители попадают в ткани и стимулируют иммунную систему в виде ГЗТ. При этом происходит созревание грануляционной ткани в грубоволокнистую соединительную ткань. По этой причине для склеромной гранулемы характерно выраженное и избыточное развитие соединительной ткани, в основном в слизистой оболочке верхних дыхательных путей. Бурное склерозирование приводит к стенозу просветов носа, гортани, трахеи и даже бронхов, что затрудняет поступление воздуха в легкие и несет угрозу асфиксии. При этом также отсутствует приобретенный иммунитет.
Таким образом, все специфические иммунные гранулемы имеют много общего в своей морфологии, морфогенезе, иммунологических процессах и биологической целесообразности.
Неиммунные гранулемы возникают вокруг инородных тел и в результате действия пыли, дыма, аэрозолей, суспензий. При этом возможно образование фагоцитом или гигантоклеточных гранулем. Обязательный элемент таких гранулем - макрофаг, осуществляющий фагоцитоз, незначительное количество лейкоцитов, в том числе эозинофилов, а также гигантских клеток инородных тел. Как правило, в таких гранулемах нет эпителиоидных клеток, много сосудов. Неиммунные гранулемы характерны для ряда профессиональных заболеваний (силикоз, талькоз и др.).
Гранулематозные болезни
Гранулематозные болезни - группа заболеваний различной этиологии, основным морфологическим выражением которых являются различные гранулемы, нередко в сочетании с васкулитами. Гранулематозное воспаление лежит в основе более 70 заболеваний, и количество их постоянно увеличивается. Патогенез болезней с наличием иммунных гранулем определяют реакции иммунной системы, а заболеваний с образованием неиммунных гранулем - природа повреждающего фактора. Те и другие заболевания текут хронически, с развитием в органах склеротических процессов, нарушающих их функции.
Воспаление вокруг животных паразитов и инородных тел
Эти виды гранулематозного воспаления характеризуются продуктивной реакцией, направленной на отграничение раздражителей от окружающих тканей соединительнотканной капсулой, так как они не могут быть фагоцитированы и элиминированы. Поэтому вокруг таких инородных тел (осколок снаряда, пуля, стекло и т. п.) возникают грануляционная ткань и инфильтрат из лимфоцитов, эозинофильных гранулоцитов, фибробластов, макрофагов и гигантских клеток инородных тел. Некоторые инородные тела (например, остатки шовного материала после операции) могут быть ликвидированы в динамике продуктивного воспаления с помощью макрофагов и гигантских клеток. В случае гибели раздражителя процесс заканчивается образованием рубца. Инфильтрат вокруг животных паразитов, помимо перечисленных клеток, обычно содержит эозинофильные гранулоциты. Погибшие животные паразиты (трихинеллы, цистицерки и др.) нередко петрифицируются (рис. 4.13).

Гиперпластические разрастания
Гиперпластические (гиперрегенераторные) разрастания - результат продуктивного воспаления в строме слизистых оболочек. На фоне пролиферации клеток стромы возникают инфильтраты из эозинофилов и лимфоцитов и происходит гиперплазия эпителия слизистых оболочек. При этом возникают воспалительные полипы - полипозный ринит, полипозный колит и т.п. Разумеется, они названы полипами только из-за внешнего сходства с истинными полипами, в основе которых лежит опухолевая пролиферация.
Гиперпластические разрастания бывают также на границе слизистых оболочек с плоским либо призматическим эпителием. Они являются результатом постоянного раздражающего действия отделяемого слизистых оболочек, например, в прямой кишке или женских наружных половых органах. При этом происходит мацерация плоского эпителия, а в строме возникает хроническое продуктивное воспаление, приводящее к разрастанию стромы, эпителия и образованию остроконечных кондилом. Наиболее часто они бывают вокруг заднего прохода и наружных половых органов, особенно у женщин.
ИММУННОЕ ВОСПАЛЕНИЕ
Иммунное воспаление - ответная реакция на впервые возникший иммунологический конфликт в сенсибилизированном организме, в результате чего чужеродный антиген или аутоантиген должен быть элиминирован. Это понятие ввел А.И. Струков (1979). Он показал, что морфологической основой реакций ГНТ (анафилаксии, феномена Артюса и т.п.) и ГЗТ (туберкулиновой реакции) является воспаление, начало которого связано с иммунными реакциями. Пусковым механизмом воспаления служит повреждение тканей при действии на них иммунных комплексов антиген-антитело, комплемента и ряда медиаторов иммунитета.
Морфологические изменения, возникающие при иммунном воспалении, развиваются в определенной последовательности:
-
образование нерастворимых иммунных преципитатов (комплексов антиген-антитело) в просвете венул (при феномене Артюса и т.п.) или артерий (при иммунокомплексной болезни и т.п.);
-
хемотаксическое действие преципитатов на полиморфно-ядерные лейкоциты, их скопление в стенках вен и капилляров либо артерий и вокруг них;
-
высвобождение лизосомальных ферментов лейкоцитов и образование вазоактивных веществ;
-
фагоцитоз и переваривание иммунных комплексов полиморфно-ядерными лейкоцитами с помощью ферментов лизосом;
-
повреждение вазоактивными веществами сосудистой стенки с развитием в ней фибриноидного некроза и последующими периваскулярными кровоизлияниями, отеком окружающих тканей.
В результате иммунного воспаления в пораженной зоне развивается экссудативно-некротическая реакция с серозно-геморрагическим экссудатом.
При реакции ГЗТ основная роль в очаге воспаления принадлежит T-лимфоцитам и макрофагам. Они находят в ткани антиген и, уничтожая его, вместе с ним разрушают ткани. Изменения микроциркуляторного русла при этом выражены слабо, полиморфно-ядерные лейкоциты отсутствуют или их мало. Инфильтрат представлен в основном лимфоцитами, макрофагами, нередко гигантскими клетками. Воспаление протекает по типу продуктивного (гранулематозного или реже межуточного). Характерно затяжное течение.
Контрольные вопросы
-
Что такое медиаторы воспаления и какова их роль в возникновении и течении воспалительной реакции?
-
Что такое антимедиаторы воспаления и какова их роль в воспалительной реакции?
-
Опишите пато- и морфогенез стадии альтерации и каково ее значение в воспалении?
-
Дайте определение экссудативному воспалению и назовите его виды.
-
Что такое пиогенная мембрана абсцесса и чем она представлена?
-
Что такое продуктивное (пролиферативное) воспаление. Назовите его виды.
-
Назовите виды гранулематозного воспаления и укажите особенности строения различных гранулем.
-
Что такое иммунное воспаление и каковы его морфологические особенности?
-
В чем заключается биологический смысл и целесообразность воспаления?
Список литературы
Пауков В.С. Воспаление // Патология: Руководство. - М.: ГЭОТАР-Медиа, 2002. - С. 89-127.
Пауков В.С., Ромаданова Н.Б., Фокина М.А. Воспаление // Патология / под ред. М.А. Пальцева, В.С. Паукова. - М.: ГЭОТАР-Медиа, 2008. - Т. 1. - Гл. 4. - С. 127-182.
Струков А.И., Пауков В.С., Кауфман О.Я. Воспаление. Общая патология человека: Руководство / под ред. В.В. Серова, Д.С. Саркисова. - М.: Медицина, 1990. - Т. 2. - Гл. 8. - С. 3-74.
Струков А.И., Серов В.В. Патологическая анатомия / под ред. В. С. Паукова. - М.: ГЭОТАР-Медиа, 2013. - 878 с.
Воспаление: Руководство / под ред. В.В. Серова, В.С. Паукова. - М.: Медицина, 1995. - 640 с.
Шлопов В.Г. Патологическая анатомия. - Донецк: Каштан, 2010. - Гл. 9. - С. 133- 153.